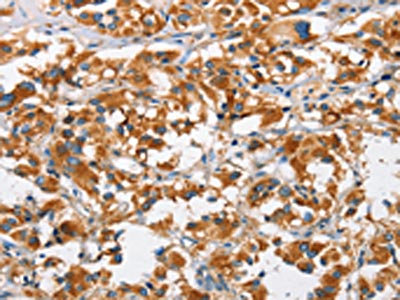
CSB-PA037884

DKK3
DKK3,即DickkopfWNT信號通路抑制因子3,別名Dickkopf-3。它是一種分泌性糖蛋白,屬于DKK相關蛋白家族成員之一。DKK3主要通過調(diào)節(jié)經(jīng)典Wnt/β-catenin信號通路發(fā)揮作用,具有調(diào)控組織發(fā)育、凋亡、增殖、代謝和免疫反應等多種重要生物學功能。DKK3在心臟疾病、腫瘤、免疫調(diào)節(jié)通路、神經(jīng)發(fā)生及代謝性疾病方面均有研究,尤其在心臟疾病及腫瘤等方面,DKK3的相關生物學功能及其與人類疾病的相關性使其可以作為相關人類疾病診斷以及治療的一個重要分子標志物。DKK3在心血管疾病包括心力衰竭和腎臟疾病中的作用被特別關注,研究表明,DKK3在心臟可能具有保護作用,但在腎臟可能具有不利影響。DKK3作為新興的生物標志物,其在血漿和尿液中的水平與心血管疾病和腎臟疾病的發(fā)生發(fā)展有關。
熱銷產(chǎn)品
驗證數(shù)據(jù)
The image on the left is immunohistochemistry of paraffin-embedded Human thyroid cancer tissue using CSB-PA037884(DKK3 Antibody) at dilution 1/50, on the right is treated with fusion protein. (Original magnification: ×200)

The image on the left is immunohistochemistry of paraffin-embedded Human brain tissue using CSB-PA037884(DKK3 Antibody) at dilution 1/50, on the right is treated with fusion protein. (Original magnification: ×200)

Gel: 8%SDS-PAGE, Lysate: 40 μg, Lane: Human fetal brain tissue, Primary antibody: CSB-PA037884(DKK3 Antibody) at dilution 1/200, Secondary antibody: Goat anti rabbit IgG at 1/8000 dilution, Exposure time: 40 seconds
DKK3 Antibodies
DKK3 for Homo sapiens (Human)
| 產(chǎn)品貨號 | 產(chǎn)品名稱 | 種屬反應性 | 應用類型 |
|---|---|---|---|
| CSB-PA006922GA01HU | DKK3 Antibody | Human,Mouse | ELISA,WB |
| CSB-PA694792 | DKK3 Antibody | Human | ELISA,WB |
| CSB-PA008861 | DKK3 Antibody | Human,Mouse | WB, ELISA |
| CSB-PA274333 | DKK3 Antibody | Human,Mouse | ELISA,IHC |
| CSB-PA037884 | DKK3 Antibody | Human,Mouse | ELISA,WB,IHC |
| CSB-PA890660LA01HU | DKK3 Antibody | Human | ELISA |
| CSB-PA890660LC01HU | DKK3 Antibody, FITC conjugated | Human |
DKK3 Proteins
DKK3 Proteins for Homo sapiens (Human)
| 產(chǎn)品貨號 | 產(chǎn)品名稱 | 來源 |
|---|---|---|
| CSB-YP890660HU CSB-EP890660HU CSB-BP890660HU CSB-MP890660HU CSB-EP890660HU-B |
Recombinant Human Dickkopf-related protein 3 (DKK3) | Yeast E.coli Baculovirus Mammalian cell In Vivo Biotinylation in E.coli |
DKK3 ELISA Kit
DKK3 ELISA Kit for Homo sapiens (Human)
| 產(chǎn)品貨號 | 產(chǎn)品名稱 | 樣本類型 | 靈敏度 |
|---|---|---|---|
| CSB-E13607h | Human Dickkopf 3,DKK3 ELISA Kit | serum, plasma, tissue homogenates | 7.8 pg/mL |
















